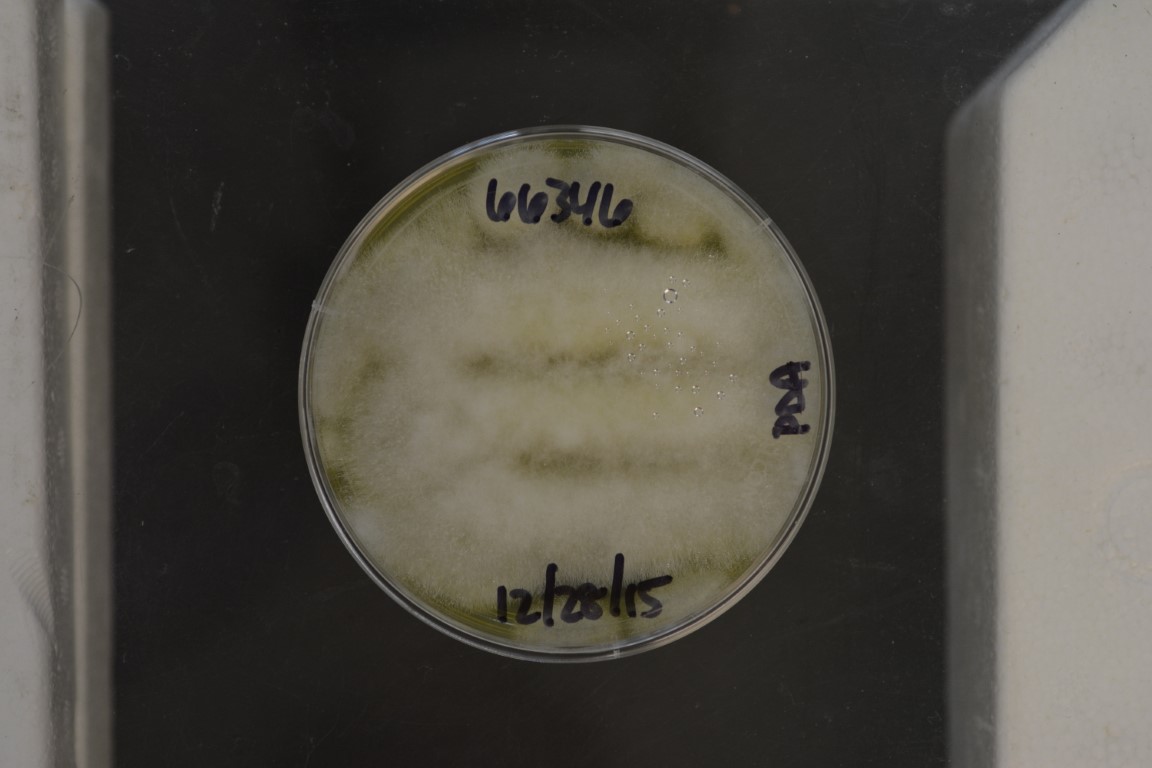
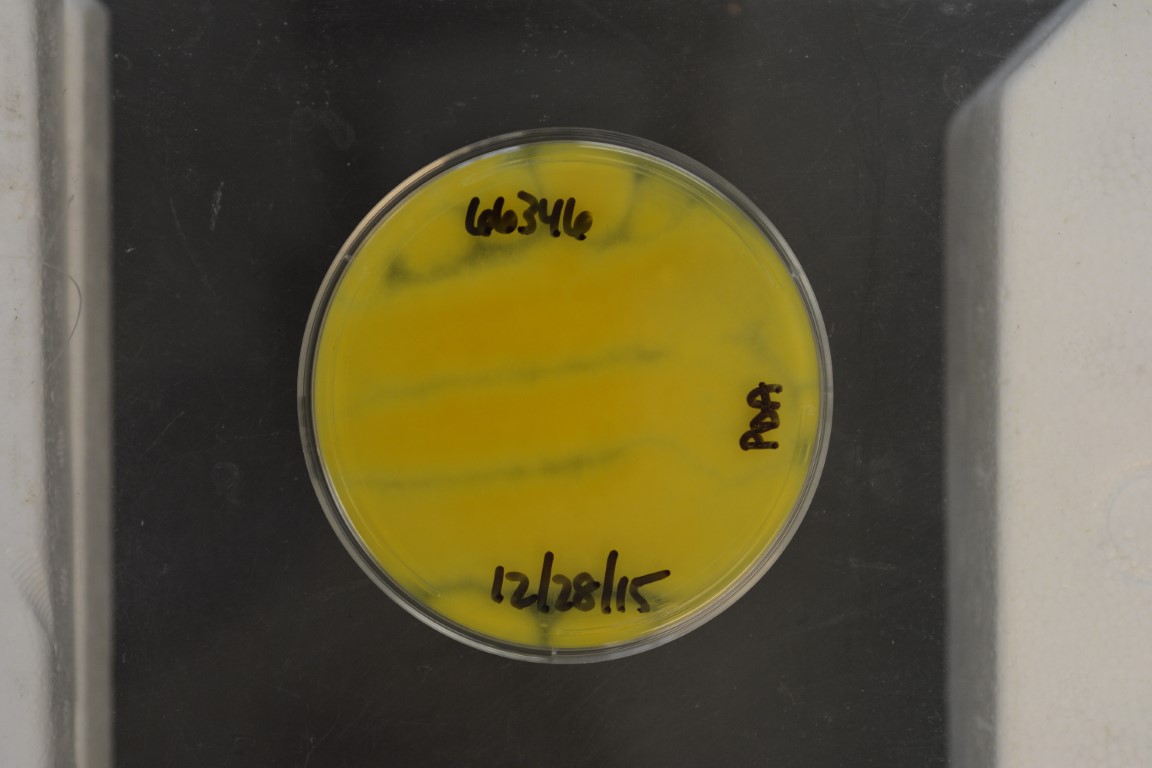

Penicillium paradoxum
NRRL 66346
Accession numbers in other collections:z-2666
Source:SW Peterson,NCAUR,Peoria,IL,Zeljko Jurjevic
Isolated from(substrate):bathroom,settle plate
Substrate location:Pantego,TX December 2014,USA
Growth media:Potato Dextrose Agar(number 3)
Optimum growth temperature:25C
Strain images:
NRRL_66346_3_reverse.jpg

NRRL_66346_3_top.jpg

NRRL66346